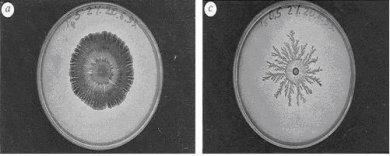

Morfogénesis y emergencia de patrones en sistemas biológicos: del rompimiento de simetría a la autoorganización y la excitabilidad(NOTA 1)
Agradecemos a los doctores Enrique Ruelas Barajas, Ricardo Mansilla, Javier Rosado, coordinadores del libro, así como al autor del artículo la autorización para su publicación.
Este capítulo expone de manera conceptual algunos mecanismos subyacentes a la emergencia de patrones en sistemas biológicos, así mismo presenta su formulación matemática y algunos ejemplos. Para facilitar su lectura se ha organizado por secciones, cada una de las cuales aborda una temática específica. El espectro de los sistemas que se utilizan para ejemplificar es amplio, y por ello, lo mismo se habla de los mecanismos que hacen posible la aparición de manchas o franjas en el pelo de algunos felinos, que del patrón que sigue un potencial de acción cuando viaja por el músculo cardiaco en estado de fibrilación. Finalmente menciona algunas extensiones que complementan lo que aquí se incluye, y hace algunas reflexiones sobre el papel que juega la dinámica no lineal, gracias a la cual es posible explicar la emergencia de patrones en los sistemas biológicos.
Introducción
Basta dar una mirada a nuestro entorno para advertir que la vida se manifiesta de formas muy diversas: una de ellas, por demás conspicua, es el tamaño. En efecto, hay individuos tan diminutos como la Mycobacteria tuberculosis, que mide apenas 1 yoctómetro (ym) de longitud; mientras que también existen de gran tamaño como el árbol Sequoiadendron giganteum, que alcanza hasta 150 m de altura, lo cual, en términos de órdenes de magnitud, equivale a 1026 ym, es decir, ¡veintiséis órdenes de magnitud de diferencia entre una y otro! A la gran diversidad de tamaños se añade la multiplicidad de morfologías. Sin embargo, en lo que hace a las posibilidades imaginables en torno a los organismos, no todas son posibles pues, dada cierta escala espacial, un ser vivo no puede tener una forma arbitraria, ya que hay restricciones que imponen las leyes físicas. Por ejemplo, es factible imaginar una hormiga del tamaño de un elefante, sin embargo las restricciones antes mencionadas impiden su existencia real… ya que simplemente se colapsaría bajo su propio peso. Por lo tanto, la interacción de la geometría y la física restringen la variedad de formas de los organismos.
Al abundar sobre la diversidad biológica, invariablemente se llega al aspecto externo que muestran los seres vivos. De nueva cuenta aquí, tanto por el colorido, como por el tipo de regularidades, la variedad resulta tan pasmosa que parece inaprensible. Se puede citar como ejemplo el caso de algunas víboras, cuya parte ventral es distinta de lo que se observa en la dorsal. En ésta —según la especie—, lo mismo se aprecian anillos o bandas de diferente ancho con coloración alterna (como en la coral de la familia Elapidae que tiene franjas roja-amarilla-negra-amarilla-negra-roja, cabe aclarar que el anillo amarillo es menos ancho que los otros dos). En otros casos, las franjas son longitudinales con colores o manchas en forma de diamante. También hay otras en las cuales las manchas están formadas por motas más pequeñas. El monstruo de Gila es un reptil particularmente atractivo en este sentido, pues en su cola posee bandas alternas de colores, mientras que en el resto de su cuerpo, éstas están compuestas por motas.
Los patrones de coloración en algunas especies de peces constituyen un auténtico museo, dado que en un mismo individuo se presentan estructuras que tienen muy diferente aspecto geométrico, como se observa en la figura 1, en la cual se ve un pez en cuya parte más ancha aparecen —sobre un fondo blanco— manchas, algunas de forma hexagonal, pero hacia su parte trasera hay una transformación cualitativa en la sucesión de patrones; por ejemplo, en la cola, tiene franjas que se alternan con motas.

Figura 1
La formación de algunas estructuras ordenadas es resultado de procesos colectivos en los que participan no unos pocos individuos, sino muchos. En ciertos sistemas, se hallan involucradas escalas de longitud que van de la dimensión de un solo individuo a la que caracteriza a todo el conglomerado; en estos casos el comportamiento individual nada indica –o indica muy poco– de lo que sucede con la colectividad. Si bien, se pueden mencionar numerosos ejemplos hay uno que además de vistoso ha sido cuidadosamente estudiado: el de la bacteria Bacillus subtilis, cuyas colonias, según las condiciones ambientales en las que crecen, son capaces de modificar su distribución espacial y exhibir diversas geometrías; en un cultivo forman estructuras que van desde algunas ramificadas con aspecto fractal, hasta las denominadas estructuras morfológicas densas. En la figura 2 se muestran dos diferentes patrones de colonias formados por esta bacteria.
Figura 2
En este punto resulta pertinente llamar la atención del lector en torno a una serie de procesos que ocurren de manera secuencial y culminan con la formación de un vertebrado. Al estudiarlos –así sea someramente– podremos tener una idea de lo complicados e interesantes que son. Nos referimos a los individuos que tienen su origen en la fecundación de un óvulo por un espermatozoide. Como es conocido, cuando éste es fecundado, se le llama huevo, el cual por mitosis y sin un aumento en su volumen, da lugar a un conjunto de células hijas prácticamente idénticas. Éstas forman un agregado llamado mórula, porque su aspecto nos recuerda al de una mora. A continuación, las células internas de dicha mórula migran hacia la parte externa por lo que dejan un hueco en el interior. Esta nueva estructura del desarrollo embrionario recibe el nombre de blástula. Posteriormente, debido a diferencias de presión, surge, a partir de un punto (el blastoporo), el proceso de gastrulación, el que, a su vez, se inicia con la invaginación de la blástula, lo que da origen a dos capas de células: una interna, llamada endodermo y otra externa, denominada ectodermo (véase la figura 3).

Figura 3
Poco después, las células que rodean al blastoporo se introducen entre el ectodermo y el endodermo para producir una tercera capa de células: el mesodermo. A partir de estas tres capas celulares primitivas —que en todo vertebrado se forman— se originan los tejidos, órganos y sistemas. En efecto, el acercamiento de las células —que originalmente estaban distantes—inicia un proceso fundamental en el desarrollo del embrión: su diferenciación, la cual rompe la casi homogeneidad celular original, para dar lugar a células diferenciadas. Expresado en otras palabras, esta diferenciación comprende en sí, una serie de procesos mediante los cuales “se le indica” a cada célula qué parte (y función) del cuerpo le toca desarrollar (realizar): células del hígado, del corazón, de las uñas, de los pies, de los dientes, etc. De hecho, se sabe cuáles órganos tienen su origen en las células que constituyen cada una de las tres capas mencionadas; de las que integran el ectodermo se forma la epidermis y las células nerviosas; de las del endodermo derivan el revestimiento del tubo digestivo y varias glándulas; mientras que las del mosodermo dan lugar a músculos, tejido conjuntivo, cartílagos, huesos, sangre; del labio dorsal del blastoporo, proviene el sistema nervioso.
La comprensión puntual de cada etapa del desarrollo que hemos descrito de manera esquemática, permitiría responder preguntas como: ¿cuáles son los mecanismos químicos que producen cada etapa de desarrollo?, ¿cuáles mecanismos hacen posible la diferenciación celular durante el desarrollo, de manera que todo ese proceso culmine con la formación de un individuo con simetrías espaciales?
Más allá de los detalles específicos de cada proceso —que sin duda son muy importantes y a lo que han dedicado su trabajo numerosos investigadores— el lector debe advertir que lo descrito en el penúltimo párrafo constituye un continuo cambio de estadios; un tránsito por distintos estados de desarrollo: del huevo a la mórula; de ésta, a la blástula, de la cual se pasa a la diferenciación celular. En términos dinámicos, la transición de un estadio a otro puede caracterizarse como un rompimiento de simetría que conduce a una nueva simetría. Pongamos por caso, los humanos somos individuos que, en cuanto a nuestra morfología externa, tenemos algunas simetrías, quizás la más visible de éstas sea la axial: dos ojos, dos piernas, dos brazos, dos manos, cada miembro ubicado simétricamente respecto a una recta vertical que nos parte en dos. Pero no sólo nos distingue esta característica, también somos entes ordenados temporal y funcionalmente, pues ciertas partes de nuestro cuerpo se desarrollan a medida que crecemos.
La emergencia de estructuras ordenadas atañe a los sistemas biológicos. Sin embargo, en el mundo inanimado, y como resultado de los más variados procesos, también emergen muchas estructuras ordenadas, que pueden aparecer en sistemas tan disímiles como: reacciones químicas, mezcla de fluidos con diferente viscosidad o las dunas del desierto. En lo que se refiere a estas últimas, de seguro todos hemos visto alguna fotografía de un desierto, en la cual son notorias ciertas estructuras onduladas de arena que son el resultado de la interacción entre ésta y el viento. El tipo y tamaño del grano de la arena, la inclinación de la superficie, la dirección e intensidad del viento, etc., son factores que influyen en la formación de ondulaciones en apariencia caprichosas (véase la figura 4).
Los ejemplos mencionados exhiben estructuras ordenadas que de manera genérica, reciben el nombre de patrones. Algunos de ellos son resultado de dinámicas internas (endógenas) de los sistemas, es decir, emergen en virtud de un proceso de autoorganización que, a su vez, deriva de la interacción no lineal de sus elementos constituyentes. Más allá de lo impresionante que pueda parecer la diversidad de patrones tanto en sistemas orgánicos como inorgánicos, debemos apuntar que su sola observación nos lleva invariablemente a preguntarnos cuál es su origen, expresado en otras palabras, al estudio de la morfogénesis.(NOTA 3)

Figura 4
El origen y la evolución de las formas vivas constituye un problema fundamental en la biología del desarrollo. Sin embargo, la búsqueda de explicaciones que hagan posible entender la emergencia de estructuras ordenadas en biología ha recorrido caminos que, por decir lo menos, son polémicos. Por ejemplo, se podría pensar que la formación de los patrones biológicos depende de la genética, pero diversas investigaciones han permitido determinar que si bien tiene algo que ver en estos complicados procesos, por sí misma no genera los mecanismos que los hacen posibles. La teoría de la evolución por selección natural propone otro tipo de “explicación”, y propone que los organismos actuales se originaron por un proceso de diversificación y de adaptación de algunos antepasados primitivos, los que, a su vez, descienden de sus antepasados y éstos de sus ancestros y así sucesivamente. Según este planteamiento, la morfología de los seres vivos es como la vemos, debido a las ventajas adaptativas que les confiere el tener tales o cuales características de las que carecen otros. No obstante, esto no explica nada, sino que se limita a hacer un recuento histórico de lo sucedido. Así, cuando se argumenta que la morfología (incluido el aspecto externo) de los organismos es como es debido a procesos adaptativos, ya no hay nada que discutir, todo está dicho...¡pero nada ha sido explicado!
Una propuesta de explicación
Invitamos al lector a que juntos recorramos un camino que nos conducirá a la formulación de uno de los mecanismos morfogenéticos más populares. Iniciamos nuestro periplo centrando la atención en un personaje muy singular y conspicuo, nos referimos al científico escocés D’Arcy Wenworth Thompson, quien, con elegancia y profundidad de pensamiento, escribió On Growth and Form,(NOTA 4) En esta obra al referirse a la morfología de los seres vivos, toma partido por la objeción expuesta en el último párrafo y lo hace así:

Figura 5
“El hecho de que muchas formas biológicas parezcan seguir reglas matemáticas o geométricas sencillas, indica que la existencia de fuerzas de constricción en su crecimiento es una explicación más parsimoniosa que la selección natural.”
En congruencia con esta perspectiva y en forma por demás audaz, D’Arcy Thompson se percató de que al transformar una rejilla (un sistema de coordenadas) que previamente había superpuesto al dibujo de algunos organismos, obtenía otro de diferente especie. En la figura 5 se muestra la transformación del pez Polyprion en Pseudopriacathus altus.
En lo que atañe a la búsqueda de los mecanismos que hacen posible la emergencia de patrones, el científico escocés, aduce:(NOTA 5)
“Célula y tejido, concha y hueso, hoja y flor son otras tantas porciones de la materia y es obedeciendo a las leyes de la física que sus partículas se han movido, moldeado y conformado... Sus problemas de forma son en primera instancia, problemas matemáticos, sus problemas de crecimiento son, esencialmente, problemas físicos y el morfólogo es ipso facto, un estudioso de las ciencias físicas.”
Lo que expresa D’Arcy Thompson resulta tan simple como profundo: no interesa si se trata de organismos vivos o de materia inerte, lo importante es que unos y otra están hechos de materia que obedece leyes físicas. Por ende, la emergencia de estructuras ordenadas —en particular en los seres vivos— es consecuencia de procesos fisicoquímicos, y de ser así, dado que algunas de las leyes que rigen a éstos se expresan en términos matemáticos, entonces, en última instancia, las matemáticas se hallan en la base de los mecanismos subyacentes que están detrás de la emergencia de las estructuras. Este planteamiento de D’Arcy termina con cualquier visión creacionista o con las seudoexplicaciones.
En esta misma línea de pensamiento encontramos a otro científico inglés. Esta vez se trata de un matemático: Alan Mathison Turing quien, como es sabido, hizo contribuciones fundamentales a la criptografía, la lógica computacional y fue el creador de la moderna computadora. Entre sus inquietudes intelectuales, también está la morfogénesis, tema al que ha hecho contribuciones de forma igualmente destacadas. En su muy citado (NOTA 6) artículo: The chemical basis of morphogenesis,(NOTA 7) publicado en 1952, propuso un mecanismo morfogenético basado en la ocurrencia de procesos físicos simples y establece:
“...la teoría propuesta no hace uso de nuevas hipótesis, sólo sugiere que ciertas leyes físicas bien conocidas serían suficientes para dar cuenta de muchos de los hechos [de la morfogénesis]”.
De manera más explícita plantea:
“Se ha sugerido que un sistema de sustancias químicas, llamadas morfógenos, que reaccionan y se difunden juntas a través de un tejido, es el adecuado para describir el principal fenómeno de la morfogénesis. Tal sistema, aunque originalmente pueda estar bastante homogéneo, tiene la capacidad de desarrollar, más tarde, patrones o estructuras debido a una estabilidad del equilibrio homogéneo la cual es disparada por perturbaciones al azar.”
Lo que nos dice el matemático y computólogo inglés, en lenguaje un tanto técnico, es que la emergencia de patrones proviene de una bifurcación, de un rompimiento de simetría y que, subyacentes a éstos, hay dos procesos fundamentales que ocurren en forma simultánea: la reacción química de sustancias y su difusión.
La propuesta de Turing puede expresarse en términos matemáticos; aquí sólo hacemos una presentación conceptual de la misma, los detalles técnicos pueden revisarse en su artículo original o bien en otras referencias.(NOTA 8) Con tal fin, debemos introducir algunos conceptos: las ecuaciones que describen los procesos difusivos se deducen a partir de dos leyes básicas:
1. La de la conservación de la materia, según la cual, ésta en su constante transformación cambia de forma, pero su cantidad total se conserva. En el caso de procesos difusivos, esto significa que si una sustancia se difunde, entonces —si no hay fuentes ni sumideros— la cantidad que entra a cierta región es la misma que sale de ella.
2. La de Fick, la cual establece la direccionalidad en el flujo de una sustancia y lo expresa así: el flujo se da en la dirección en la que más cambia la concentración. En caso de que el flujo se dé en un espacio de dimensión uno, esta ley establece que la sustancia fluye (se difunde) de los sitios de alta concentración, hacia aquellos donde la concentración es baja;
Mientras que los conceptos correspondientes para la parte reactiva tienen su origen en una ley cinética: la de Acción de Masas,(NOTA 9) según la cual, bajo ciertas premisas,
“...la velocidad de una reacción química es directamente proporcional al producto algebraico de la concentración de las sustancias reaccionantes”.
Lo novedoso de la propuesta de Turing fue que supuso la ocurrencia simultánea de los dos procesos. En efecto, la difusión por sí sola —que tiende a homogeneizar la distribución de las sustancias en un medio— no es capaz de producir distribuciones que se aparten de lo muy trillado: ”todo igual”, todo homogéneamente distribuido. Tampoco los procesos puramente cinéticos dan origen a estructuras ordenadas en el espacio. En el planteamiento turingiano, se requiere que ambos procesos ocurran; aunque no siempre reaccionen y se difundan determinadas sustancias, se producirán patrones, pero es menester que lo hagan de forma “apropiada”.(NOTA 10) Las condiciones específicas derivan de imponer al sistema no lineal de ecuaciones diferenciales parciales de tipo reacción y difusión(NOTA 11) —que corresponden a la formulación matemática de los dos procesos postulados por Turing— las dos restricciones contenidas en la segunda de las citas del matemático inglés. Por ejemplo, si se consideran sólo dos reactivos, y su concentración en el tiempo t y en el punto P, los denotamos por A (t, P) y B (t, P), respectivamente, que se interpretan de la siguiente forma: la existencia de un punto, (A*,B*) en el espacio de las concentraciones que es estable ante perturbaciones temporales, pero inestable ante perturbaciones espacio-temporales. De esta manera, según este matemático, la distribución espacial de la concentración de los morfógenos evolucionará, a medida que la reacción avance, hacia una distribución espacial inhomogénea de las sustancias, pero regular: éstos son los patrones de Turing.
A fin de que el lector tenga una idea de qué tipo de consecuencias entraña, exponemos dos: 1. uno de los reactivos debe actuar como activador; mientras que el otro como inhibidor; 2. uno de los morfógenos debe difundirse más rápido que el otro.
Los ejemplos siempre ilustran
Para el primer caso —acorde a su mecanismo— nos dio un ejemplo el propio Turing, quien a pesar de lo rudimentario de los recursos computacionales que en ese tiempo se tenían, resolvió numéricamente un sistema de reacción-difusión, y obtuvo lo que llamó patrones moteados; la figura 6 muestra el resultado de sus simulaciones.
Durante algunos años el ahora clásico trabajo de Turing no fue muy conocido o se le vio con escepticismo, conforme ha transcurrido el tiempo se le ha reconocido su importancia hasta que se le ha colocado en el sitio que le corresponde: una piedra angular en los intentos por explicar los mecanismos subyacentes a la emergencia de patrones no estrictamente biológicos. Así, a la fecha no son pocos los investigadores que se han basado en el mecanismo turingiano para explicar la aparición de formas en los más variados sistemas y escalas espaciales. A continuación presentamos sólo unos cuantos:

Figura 6
Se sabe que la coloración del pelambre de algunos mamíferos la dan los melanocitos, que están en la parte basal de la epidermis, los cuales producen la melanina que pasa al pelo y le confiere color. Los mamíferos tienen dos clases de melanina: la eumelanina que genera coloración negra o café y la faeomelanina que da el amarillo o el anaranjado. Los melanocitos pueden producir o no melanina, dependiendo de la presencia o la ausencia de activadores o de los inhibidores: En otras palabras, es una sustancia que favorece la producción o la inhibición de estos últimos . La formulación matemática se lleva a un sistema de reacción y difusión, cuya parte reactiva se propone con base en la evidencia experimental disponible sobre la producción de este tipo de sustancias en mamíferos. Una vez que se precisa el rango de los parámetros que predice el análisis de Turing, se procede a resolver numéricamente el sistema en la “región modelo” que simule la parte física real en la que emerge el patrón. En la figura 7 se muestran los resultados numéricos obtenidos por Jim Murray, (NOTA 12) quien estudió la aparición de manchas en el pelambre de felinos.

Figura 7
Cabe mencionar que también se han hecho estudios numéricos sobre sistemas que han sido propuestos como explicaciones de los patrones con base en los cuales se forman las conchas de moluscos. En éstos, además de los mecanismos de reacción y difusión se presenta la quimiotaxis.(NOTA 13) El parecido entre las simulaciones numéricas y los patrones reales es sorprendente.
Consideraciones en torno a una de las críticas a la teoría de Turing
Aunque se han expuesto varias,(NOTA 14) una de las que se esgrime con mayor frecuencia como objeción a la propuesta de Turing aduce que el matemático inglés considera que las regiones en las cuales emergen las estructuras ordenadas son fijas, cuando en la realidad esto no sucede así, pues los individuos crecen y con no poca frecuencia, lo hacen de manera tal que las proporciones entre sus dimensiones lineales (talla, ancho y espesor característicos) no se conservan. Hay muchos ejemplos que muestran que el crecimiento constituye un factor fundamental en la selección del tipo de patrones. Uno de ellos, que es particularmente vistoso, es el pez Pomacanthus semicirculatus. Cuando este animal llega a los dos meses de edad, su cuerpo tiene sobre un fondo oscuro tres franjas claras; a los seis meses se ve que por cada dos surge una tercera; a los doce meses, cuando ya es adulto muestra algunas bifurcaciones, y por cada dos que poseía también aparece una tercera (véase la figura 8). De manera sorprendente, hay una variedad de este pez que, además de los cambios descritos, en la etapa adulta ya no muestran franja alguna, mientras que a otros no sólo les cambia el número de franjas, sino la orientación de las mismas.

Figura 8
En parte este fenómeno nos motivó a indagar y en 2004 propusimos(NOTA 15) un marco teórico de carácter general que permitiera no sólo estudiar el caso particular antes descrito, sino situaciones en las que emergen patrones en dominios que no únicamente cambian al aumentar de tamaño, sino que además modifican la forma. Nuestro enfoque ha tenido como punto de partida la noción turingiana, es decir, suponemos que procesos fundamentales como la reacción y la difusión se hallan en la base de la emergencia de patrones. Al escribir las ecuaciones, las cuales consideran que cambian tanto el tamaño como las características locales (curvatura) del dominio, obtuvimos un sistema en cuya parte estrictamente difusiva aparecen términos de dicha difusión: advección y dilución, dependientes del espacio y del tiempo; mientras que la cinética usada fue de tercer orden. Lo que nos llevó a incorporar este tipo de cinética tuvo su origen en estudios previos, los cuales sugieren que cinéticas de primer orden favorecen la aparición de franjas; mientras que las de segundo orden, propician la emergencia de motas.(NOTA 16) Por ende nos propusimos averiguar además, el efecto de este tipo de cinética. En otra parte del trabajo que desarrollamos, obtuvimos soluciones numéricas del sistema no lineal al considerar regiones con distintas características geométricas. Para ello se supuso que el crecimiento es isométrico, dicho en otras palabras: se da en la misma proporción en todas las direcciones.
Con la finalidad de estudiar sólo el efecto del crecimiento se tomó un cuadrado, que, como ilustra la figura 9, muestra la distribución que adopta uno de los morfógenos.(NOTA 17) Se debe hacer notar que las zonas de alta concentración del morfógeno aparecen en color m’as oscuro, mientras que las de baja tienen coloración m’as clara. El cuadrado inicial (t = 0), que se encuentra ubicado en el extremo superior izquierdo, presenta alta concentración del morfógeno en sus cuatro esquinas y en el centro. En estas simulaciones, se observaron varios fenómenos nuevos que no aparecen en cuadrados de tamaño fijo. Uno consiste en la inserción de nuevas manchas, es decir, la aparición de una nueva por cada par que había antes (esto se aprecia claramente en las primeras veinte imágenes). Desde el punto de vista cualitativo corresponde a lo que ocurre en el Pomacanthus. Otro es el adelgazamiento de las manchas hasta llegar a su partición en dos (algo que se puede observar en las últimas quince imágenes). También aparecen otras simetrías, como la caracterizada por una mancha central y otras en cada esquina de un cuadrado que después se rompe.

Figura 9
A fin de analizar el efecto combinado del crecimiento y la curvatura en la emergencia de patrones, enseguida se considera el modelo de un cono en crecimiento sobre cuya superficie lateral se desarrollan los procesos básicos de reacción y difusión antes descritos. Al realizar los estudios de tipo numérico, lo primero que se advirtió es que las características de los patrones emergentes, dependían fuertemente de la proporción entre el radio de la base y la altura del cono. Así, primero consideramos un cono en el cual esta proporción tiene valor de uno (altura = radio). Con base en la misma convención usada en el ejemplo anterior para representar la concentración de uno de los morfógenos, la figura 10 ilustra cómo varía ésta a medida que el cono crece.(NOTA 18) En la primera imagen —la del cono más pequeño— se muestra la distribución inicial (t = 0) de la concentración del morfógeno. Una vez que empieza el crecimiento y que los procesos de reacción y difusión se llevan a cabo, cambia la distribución de la concentración, según lo ilustran las imágenes sucesivas de la citada figura 10. Una de las cosas nuevas que aquí aparecen es el rompimiento del anillo inicial cerca del vértice, para dar lugar a sucesivas manchas, las cuales a su vez se alinean en una suerte de “anillos discontinuos” sobre el cono.
Como ejercicio final se hizo un estudio numérico en el cual se consideró que la altura del cono era el doble de lo que mide el radio. El resultado de estas simulaciones numéricas se ve en la figura 11. En ésta puede apreciarse que, a medida que el cono crece, la distribución espacial de la concentración del morfógeno pasa por varios transitorios. En el primero (las cinco imágenes iniciales) coexisten anillos concéntricos de alta concentración con manchas —también de alta concentración— las cuales, aparentemente, se originan por el rompimiento de anillos que paulatinamente van desapareciendo. Nótese el parecido que tienen estos patrones con los observados en la cola de algunos mamíferos. Después, viene otro bloque de imágenes en las que se observan franjas alineadas en forma helicoidal sobre la superficie del cono, las cuales, a su vez, están compuestas por franjas.

Figura 10
Con esta descripción se concluye la presente sección para dar paso a un tema fundamental en fisiología: el proceso de conducción nerviosa que nos servirá de base para la presentación de otros temas.
La neurona, una célula excitable
Los seres humanos realizamos un sinnúmero de actividades diariamente: caminamos, comemos, hablamos, respiramos, nos entristecemos o enojamos, nos ponemos eufóricos, etc. Cada una de ellas es de muy diverso tipo: motora, consciente, inconsciente, rápida, lenta. Algunas son respuestas a estímulos internos de nuestro propio cuerpo o bien reacciones ante estímulos externos. Toda esta diversidad está coordinada y dirigida por un gran director de orquesta: el sistema nervioso central (SNC), que se encuentra alojado en el cerebro y en la médula espinal, y lleva a cabo su trabajo a través de células especializadas que son su unidad funcional: las neuronas, que desde ahí se extienden a todo el cuerpo. Tenemos aproximadamente 1011 neuronas, cada una de las cuales recibe información de hasta 105 neuronas, lo que significa que integran una red muy compleja de conexiones que resulta altamente eficiente, a pesar de que a lo largo de nuestra vida perdemos muchas de ellas.
Las neuronas, conforme a la actividad específica que realicen y de su localización, pueden tener diferente tamaño y geometría, pero todas ellas poseen un núcleo o soma, una membrana y dendritas. A través de una de éstas —la de mayor diámetro, llamada axón— se transmite una señal eléctrica (el potencial de acción) por medio de la cual una neurona se comunica con otras. Dicha comunicación no se da a través del contacto físico entre las neuronas, sino que este proceso aprovecha las propiedades electroquímicas que poseen, tanto la neurona como su medio circundante.(NOTA 19) Este “puente electroquímico” recibe el nombre de sinápsis que es donde se encuentran los neurotransmisores.

Figura 11
La información que transmite la neurona viaja en una sola dirección y sólo comprende dos opciones: se difunde o no. La neurona reúne las características de un sistema de información completo: recibe información (receptor), la integra y responde (emisor) de acuerdo a los datos que recibe. En términos electroquímicos, las neuronas tienen las siguientes características:
1. Permeabilidad. Su membrana es selectiva y permite el paso (hacia adentro o hacia fuera) de los iones: deja pasar con mayor facilidad a unos que a otros. El sitio físico por el cual fluyen reciben el nombre de canales iónicos,
2. Excitabilidad. En condiciones “normales” es decir, en estado estacionario, la diferencia de potencial entre el interior y el exterior de la membrana celular, es aproximadamente de -70 mV. La aplicación de un estímulo, bajo la forma de un voltaje, puede o no modificar esta diferencia de potencial. En efecto, existe un potencial umbral, Vu, con la siguiente característica: si el estímulo aplicado es menor que el valor de Vu entonces la neurona no se da por “enterada” y el potencial de membrana regresa al valor de reposo; pero si el estímulo aplicado supera Vu, entonces la neurona lo percibe y en respuesta incrementa la diferencia de potencial (llamado ahora potencial de acción) hasta cierto valor máximo (aproximadamente 40 mV), después de lo cual decae hasta llegar de nueva cuenta al estado estacionario. Cuando esto ocurre, se dice que la neurona se excitó y entonces el estímulo se propaga a través del axón. De lo descrito aquí, debe quedar claro que si la neurona no se excita, no transmite información alguna; mientras que cuando sufre excitación deja pasar la señal bajo la forma de una diferencia de potencial,
3. Refractariedad. Si la neurona está excitada y se le estimula aplicándole un voltaje que sobrepase el potencial umbral, no reacciona. Sólo lo hace hasta que el potencial de membrana regresa a su valor estacionario. El tiempo que transcurre entre el momento en que se excita la neurona y el instante en que potencial de membrana regresa a su estado estacionario, se denomina periodo o tiempo refractario.
Con un profundo conocimiento de la parte experimental y de la modelación matemática, a principios de la década de 1950 del siglo pasado, los fisiólogos ingleses A.L Hodgkin y A.F. Huxley propusieron lo que sin duda es el marco teórico más completo para describir la propagación de los impulsos nerviosos a través del axón neuronal. Los experimentos los llevaron a cabo en el Laboratorio de la Asociación de Ciencias Marinas en Plymouth, Inglaterra, y emplearon como sujeto de experimentación al calamar Loligo pealii cuyo axón es relativamente grande (0.5 mm de diámetro y 5 cm de longitud). Los finos ensayos efectuados incluyeron por vez primera la técnica de fijación del voltaje,(NOTA 20) que consiste en introducir dos electrodos en el axón a fin de garantizar que el potencial de membrana no varíe a lo largo de aquél, de tal manera que sólo se preste atención a su variación temporal. Para construir su modelo, los fisiólogos ingleses primero se hicieron un prototipo electrónico del proceso que intentaban describir, el cual a la vez debía capturar los aspectos cualitativos de la conducción nerviosa. Constaba de los siguientes elementos: tres resistencias (cada una simulaba la oposición al paso de los iones de sodio, potasio y los de otros menos relevantes) y un capacitor, ambos conectados en paralelo. Hecha la analogía, la dinámica quedaba en manos de las leyes que rigen los circuitos eléctricos: leyes fundamentales de la electricidad y las leyes de Kirchoff (conservación de carga y de energía). La deducción detallada del modelo propuesto, rebasa los objetivos de esta presentación. Sin embargo, el lector puede revisar los detalles en la abundante literatura publicada sobre estos temas (se le recomienda el libro de Keener y Sneyd).(NOTA 21) Baste decir aquí que se trata de cuatro ecuaciones diferenciales ordinarias no lineales, acopladas: una para el potencial, otra para la variable asociada con la activación de los canales de potasio, la tercera corresponde a la activación de los canales de sodio y la cuarta a la variable de inactivación de los canales de sodio.
Los estudios analíticos del sistema de Hodgkin y Huxley no son simples, razón por la cual los primeros que realizaron los padres del modelo, los hicieron mediante el uso de técnicas numéricas. Dado el incipiente desarrollo que en esa época tenía la computación, este trabajo constituyó toda una proeza. No obstante estas limitaciones, los fisiólogos ingleses lograron describir aspectos cuantitativos, como la velocidad de propagación de los impulsos,(NOTA 22) y cualitativos, como la forma del impulso que exhibe el potencial de acción, en forma bastante razonable.
“Por sus descubrimientos relativos a los mecanismos iónicos involucrados en la excitación y la inhibición en las porciones central y periférica de la membrana celular nerviosa”, les fue conferido, junto con el fisiólogo australiano J.C. Eccles, el Premio Nobel de Fisiología o Medicina en 1963.
La formulación matemática del fenómeno de conducción nerviosa sin la técnica de fijación de voltaje, es decir, de la manera en que se propaga en el tiempo y el espacio el potencial de acción, acorde con la teoría de Hodgkin-Huxley, parte de una premisa según la cual el axón es una estructura unidimensional (como un cable delgado), y se plantea en términos de un sistema de cuatro ecuaciones diferenciales parciales no lineales y acopladas. Una de ellas —la del potencial de acción— del tipo reacción-difusión.
Transcurridos diez a 13 años después de la publicación de los trabajos clásicos de Hodgkin y Huxley, el japonés J.S. Nagumo y el estadounidense R. FitzHugh propusieron, de forma independiente, una notable simplificación del modelo propuesto por los ingleses, la cual se basó en la observación de que la escala de tiempo en la que las variables cambian es diferente. En efecto, si una variable se modifica mucho más rápido que otra, se puede considerar que en un lapso pequeño llegará a su valor de equilibrio y, por tanto, en los intervalos de variación de la segunda, permanecerá constante e igual a su valor de equilibrio. Con base en razonamientos de este tipo y el uso de un modelo que describe un oscilador (el de van der Pol) FitzHugh y Nagumo redujeron el modelo original, a sólo dos ecuaciones diferenciales parciales no lineales acopladas. Este hecho en sí mismo pudiera parecer irrelevante, sin embargo, en el presente caso lo importante es que el modelo simplificado contiene las características esenciales del proceso de conducción nerviosa.
A partir de la década de 1970, los sistemas de Hodgkin-Huxley y el de FitzHugh-Nagumo, fueron sido sometidos a infinidad de análisis, y desde entonces se han refinado los experimentos. En diversas publicaciones se han reportado los resultados de tales estudios, teóricos y experimentales. Sin temor a una posible equivocación, se puede afirmar que el fenómeno de conducción nerviosa en su ciclo de experimentación-modelación-teórico y de comprobación experimental, ha rendido muchos y buenos frutos. Las investigaciones de índole teórica han logrado predecir la existencia de otro tipo de comportamientos que han sido demostrados experimentalmente. También, como se verá en las siguientes secciones, la teoría de Hodgkin y Huxley ha servido como punto de partida para comprender otros sistemas excitables.
Las células cardiacas también tienen su corazoncito
“Cuando el corazón está enfermo, desempeña su trabajo de forma imperfecta: los vasos que provienen de él se vuelven inactivos, de manera que no los puedes percibir. Si el corazón tiembla, tiene poca potencia y se contrae, la enfermedad está avanzando y la muerte está cerca.”
Ebers Papyrus (aprox. 3500 aC)
Con frecuencia se escucha la siguiente afirmación: “el corazón es la bomba encargada de hacer llegar la sangre a todo nuestro cuerpo”, y efectivamente así es. No obstante, descubrir y entender los procesos que hacen posible esa manifestación mecánico-hidráulica, no fue una tarea fácil. En efecto, la contracción del músculo que integra el corazón, es resultado de complicados procesos eléctricos y electroquímicos. Con el fin de disponer de los elementos mínimos que nos permitan hacer una presentación conceptual de algunos aspectos dinámicos del corazón, se dedicarán unas líneas a describir la fisiología básica de nuestro vital órgano. En primer lugar se ha de considerar que su envoltura es un músculo (el miocardio) no homogéneo y altamente especializado, integrado por disposiciones de células (los miocitos) que a su vez forman fibras. El grosor del músculo cardiaco es de dos y medio a tres centímetros. En la parte interna hay cuatro cavidades: dos superiores llamadas aurículas (una izquierda y otra derecha) y dos inferiores denominadas ventrículos (uno derecho y otro izquierdo). El corazón bombea sangre a través de dos circuitos: uno conduce sangre que contiene bióxido de carbono (sangre venosa) y el otro lleva sangre rica en oxígeno. La sangre venosa, después de recorrer todo el cuerpo, llega a la aurícula derecha a través de la vena cava superior. Cuando esta aurícula se contrae, conduce su contenido por la válvula tricúspide para vaciarlo en el ventrículo derecho. A su vez, la contracción manda la sangre a los pulmones por medio de las arterias pulmonares. Ahí se da el intercambio gaseoso (de CO2 por O2) y regresa —a través de las venas pulmonares— a la aurícula izquierda desde donde, luego de pasar por la válvula bicúspide, llega al ventrículo izquierdo que, al contraerse, la expulsa para que sea distribuida a todo el cuerpo a través de los capilares periféricos. Inmediatamente después de esta fase de contracción de las cuatro cavidades, viene un breve periodo de relajación al cabo del cual, el llamado ciclo cardiaco se repite. El corazón de un adulto en reposo se contrae (palpita) unas 70 veces por minuto, lo que hace circular aproximadamente seis litros de sangre por minuto a través del cuerpo.
Ahora se revisarán, brevemente, los aspectos electroquímicos que participan de la contracción muscular cardiaca.(NOTA 23) Las células del corazón, al igual que las del sistema nervioso, al recibir un estímulo eléctrico apropiado (por arriba de cierto umbral), se excitan y entonces propagan el potencial de acción. Más aún, una vez excitadas, producen señales eléctricas que provocan su contracción para relajarse unos instantes después. La transmisión —que es muy rápida— de las señales eléctricas entre células cardiacas se da a través de sus respectivas membranas.
El potencial de acción en las células cardiacas se produce debido a la inversión, durante un tiempo breve, de la polaridad eléctrica de su membrana, que varía del potencial de reposo (de –90 mV a –65mV) a 20 mV. Estos cambios en la diferencia de potencial, se deben a la apertura de canales iónicos en la membrana, los cuales permiten principalmente el paso del flujo de iones de potasio (K+) calcio (Ca++) y sodio (Na+).(NOTA 24) El potencial de acción de las células del corazón presenta las siguientes fases: (1) Reposo, que corresponde a la situación en la cual la membrana se halla polarizada, es decir, el interior celular es más negativo que el exterior. (2) Depolarización, fenómeno durante el cual puede ocurrir que, por un lapso breve, el interior sea más positivo que el exterior. Esto se debe a que se abren ciertos canales iónicos que son selectivos al paso (hacia el interior de la célula) de iones de potasio, sodio y calcio. (3) Repolarización, que ocurre al cerrarse los canales de sodio y calcio, y cuando se abren otros canales de potasio.
Según las partes del corazón a las que pertenecen las células cardiacas, se han observado dos tipos diferentes de potencial de acción:
1. De respuesta rápida. Los cuales corresponden a las células que constituyen las aurículas, los ventrículos y las fibras de Purkinje. En la figura 12a pueden verse las características cualitativas de estos potenciales.
2. De respuesta lenta. Se encuentran asociados a las células que forman los nodos. La figura 12b muestra los potenciales de respuesta lenta.

Figura 12
Los estímulos que dan lugar al ciclo de las contracciones sucesivas de las aurículas y de los ventrículos, descritos anteriormente, provienen de señales eléctricas producidas con frecuencia regular en un conjunto de células especializadas que se encuentran en un sitio ubicado en la parte superior de la aurícula derecha, llamado nodo sinoauricular (NSA), que es el marcapasos natural del corazón. Del NSA, bajo la forma de una onda de actividad eléctrica sincronizada, la señal se propaga a las dos aurículas. Enseguida, la onda avanza hasta una zona que divide las aurículas de los ventrículos, la cual está compuesta por células no excitables, excepto en una pequeña región que constituye la única ruta eléctrica a través de la cual se comunican las aurículas con los ventrículos, llamada nodo auriculoventricular o atrioventricular (NAV). Las características eléctricas de éste hacen que la señal se retrase un décimo de segundo, lapso en que la sangre se vacía en los ventrículos. Del NAV, la señal viaja por el haz de His hasta las fibras de Purkinje, que se ramifican sobre la parte superficial externa de los ventrículos con lo que se inicia la contracción ventricular, la cual empieza —desde el exterior hacia el interior de las cavidades— en el vértice del corazón y se propaga hacia arriba, en dirección de las aurículas. Las fibras de Purkinje conducen la señal hasta cinco veces más rápido que el músculo cardiaco.
Como se sabe, el electrocardiograma (ECG) es una de las herramientas más antiguas e importantes para evaluar la actividad eléctrica del corazón y funciona mostrando el cambio en la diferencia de potencial entre sitios específicos conforme transcurre el tiempo. El ECG presenta variaciones de una persona a otra; y más aún, en una misma persona. Las características geométricas de sus registros son diferentes según el sitio en el que se coloquen los electrodos que captan la señal. Dicho registro constituye una especie de “suma” de comportamientos parciales del potencial asociado a diferentes sitios. Normalmente se colocan: uno en el pie izquierdo, uno en cada brazo y otros en distintos puntos del pecho a la altura en la que se encuentra ubicado el corazón.

Figura 13
En la figura 13 se muestra un ECG típico o “normal”; en el cual se pueden distinguir diferentes etapas u ondas: P, QRS y T. Cada una de ellas se relaciona con un diferente tipo de actividad. Por ejemplo, la onda P concuerda con la propagación del potencial por las aurículas; mientras que la PR representa el tiempo comprendido entre el inicio de la activación auricular y el correspondiente al ventricular; dura entre 0.12 y 0.2 segundos. En caso de que este periodo durase más, significaría que hay una perturbación en la conducción auriculoventricular. La onda QRS comprende el momento en que el potencial de acción se propaga por las paredes de los ventrículos. Cabe mencionar que éste es el cambio más grande y abrupto en el potencial. Durante el tiempo que abarca la onda ST todo el miocardio ventricular se depolariza. La onda T corresponde a la repolarización de las células ventriculares, es decir, representa la etapa de recuperación del tejido ventricular. En la figura 14 aparecen tres ECG de diferentes patologías.
El análisis detallado de un ECG puede arrojar información valiosa relativa a los anormalidades en el ritmo cardiaco. Por ejemplo, una oscilación continua en la onda P sugiere la existencia del fluter auricular. Una repetición rápida de la QRS indica una taquicardia ventricular; mientras que un patrón altamente irregular de la activación ventricular corresponde a una fibrilación ventricular, un fenómeno que más adelante explicaremos.
Las enfermedades cardiacas producen perturbaciones en la secuencia de excitación de las células que integran el corazón, de tal manera que la efectividad de las contracciones de este músculo puede verse reducida de manera considerable. Los diferentes tipos de perturbaciones en los patrones normales de excitación y repolarización que ocurren durante la propagación del potencial a través del miocardio, reciben el nombre genérico de arritmias cardiacas, y es posible que se manifiesten como palpitaciones más rápidas, más lentas y sin sincronía alguna.

Figura 14
Hay varios tipos de arritmias, desde las que son relativamente benignas hasta las que ponen en peligro la vida del paciente, como la taquicardia y la fibrilación ventriculares. El ritmo de excitación puede ser lo suficientemente rápido y ocasionar que los ventrículos se llenen por completo de sangre entre las contracciones reduciendo la cantidad de sangre que se libera a la circulación. Además, es posible que la activación se propague de manera desorganizada, como en el caso de una fibrilación, y ocasione que las contracciones se produzcan sin coordinación del tejido y, a su vez, ello dé como resultado una menor presión sanguínea que puede tener consecuencias fatales.
Cabe mencionar que la fibrilación auricular es la arritmia cardiaca más frecuente. Sin embargo, a pesar de su peligrosidad normalmente no es mortal. Esto se debe al hecho de que el NAV actúa como bloqueador que impide la propagación de la actividad eléctrica irregular hacia los ventrículos, por lo que éstos continúan llenándose de sangre y bombeándola, aun sin que la contracción de las aurículas sea sincronizada. La situación resulta muy distinta en el caso de la fibrilación ventricular,(NOTA 25) ya que el sistema eléctrico del corazón y el ciclo de bombeo se desorganizan por completo.
En la literatura especializada(NOTA 26) sobre este tema se ha documentado de manera fehaciente que las ondas re-entrantes constituyen el principal mecanismo que origina y hace que persistan la taquicardia y la fibrilación. La onda re-entrante se define como un desorden electrofisiológico en el cual uno o varios frentes de activación(NOTA 27) encuentran rutas de propagación cíclicas por el miocardio. El efecto que esto tiene sobre las células que se encuentran a lo largo de una de dichas rutas, es que se ven sometidas a estímulos aplicados a una alta frecuencia que terminan por suplantar al marcapasos natural (NSA). Cuando esto ocurre, tales regiones del músculo tienen su propio marcapaso. Si esto sucediera no sólo en una pequeña región del miocardio sino en varias, entonces se produciría una “insurrección celular” cuya consecuencia puede ser —si no se le da atención al paciente en los primeros diez minutos—(NOTA 28) la muerte por paro cardiaco.
La ruta que sigue la onda re-entrante puede rodear cualquier formación anatómica como el orificio de un vaso sanguíneo o una pequeña región de músculo cardiaco que haya sufrido un infarto, dado que las células que los forman ya han perdido la propiedad de excitabilidad. También es posible que suceda lo mismo en regiones del músculo cardiaco que sean refractarias desde el punto de vista funcional.
Acorde con el objetivo de este capítulo, es necesario detenerse un poco a fin de describir con más detalle la propagación de los frentes de activación de ondas re-entrantes en el caso de una fibrilación.
Si olvidamos por un momento la característica tridimensional del músculo cardiaco y lo cortamos en rebanadas muy delgadas, tendremos, para fines prácticos, una estructura bidimensional. Se han realizado estudios experimentales,(NOTA 29) los cuales muestran que la forma de las ondas de activación re-entrantes asociadas a la fibrilación corresponde, aproximadamente, a la de una espiral. A medida que una de ellas circula una y otra vez alrededor del mismo sitio, muestra la imagen de una espiral de activación que rota. El polo de ésta (el punto en torno al cual gira), puede ser estacionario, aunque también un punto en movimiento, en cuyo caso el centro de rotación cambiará continuamente y describirá, a su vez, una curva que se halla contenida en el plano en el que “vive” (actúa) la espiral en rotación. Si en estas condiciones retomamos la verdadera estructura tridimensional del músculo cardiaco, entonces la onda de activación se transformará en una superficie de activación que “vive” en un espacio de tres dimensiones, cuyas secciones transversales son espirales, una por cada corte. A esta onda se le da el calificativo de enrollada, y por la similitud que guarda con una conocida golosina, el matemático Pedro Miramontes suele llamarla de una manera que, por lo sugerente, de seguro no la olvidará a el lector: onda chocorrol.
El filamento de la onda enrollada, entendido como la unión de todos los polos de las espirales en rotación, puede ser tan simple como una recta, pero también algo más complicado como una curva con dinámica propia, que, desde luego, influye en la dinámica de toda la superficie de activación.
Antes de concluir esta sección es necesario mencionar que en 1983 Arthur Winfree(NOTA 30) publicó un artículo muy interesante sobre la dinámica cardiaca en el cual, además de narrar un suceso muy importante para la historia de la medicina, la muerte del fisiólogo George Ralph Mines, quien se ofreció de manera voluntaria como sujeto de experimentación para el estudio de la fibrilación, aporta su hipótesis de cómo resulta útil la topología para entender el papel que desempeñan los estímulos en el surgimiento de la fibrilación.
Concluye aquí la descripción de los fenómenos fisiológicos que son relevantes para este capítulo, a fin de presentar en forma sucinta algunos aspectos matemáticos asociados con ellos.
Las ondas del corazón consideradas desde la perspectiva matemática
Sin duda en los párrafos anteriores el lector se habrá percatado de la riqueza, y también de la complejidad, que comprende cada ciclo cardiaco, especialmente en situaciones patológicas. En este contexto, no es una tarea sencilla recurrir a la matemática para describir y tratar de entender los procesos dinámicos involucrados. En parte, esto se debe a los diferentes niveles de organización que participan (célula, tejido, órgano), así como a las diferentes escalas temporales en las que se llevan a cabo los procesos electroquímicos cardiacos. A pesar de estas dificultades, se han hecho esfuerzos notables desde hace varias décadas, y se han ido perfeccionando los modelos a medida que los avances tecnológicos han permitido efectuar experimentos más finos. En las líneas siguientes se ofrece al lector una mirada panorámica de este vasto campo donde confluyen la matemática y la fisiología que permite tratar de comprender los intrincados procesos dinámicos cardiacos.
De acuerdo con el nivel de organización al que se enfoque su análisis, los modelos matemáticos usados hasta ahora se pueden caracterizar como:
Locales. Su objetivo consiste en describir —para ubicaciones específicas en el corazón— la actividad eléctrica precisa en esos sitios a medida que el tiempo transcurre. Se incluyen aquí los modelos construidos para describir el potencial de acción en la membrana de una sola célula cardiaca. Así mismo, dada la forma como se registra la información en un ECG (véase la sección anterior), los modelos matemáticos asociados al análisis de la serie de tiempo, (NOTA 31) contenida en esos registros, son de carácter local. El fenómeno de propagación de ondas no a través de una célula sino de medios compuestos por muchas, conduce a otro escenario y, consecuentemente, a otro tipo de modelos.
Globales. Tienen como propósito el estudio de la dinámica de la actividad eléctrica en regiones “grandes” del corazón, no sólo conforme transcurre el tiempo, sino también a medida que varían las coordenadas espaciales. Para ello, introducen la noción de medio excitable, que se entiende como un sistema compuesto por elementos individuales (células) excitables, cada uno de los cuales tiene el mismo estado estacionario y el mismo umbral de excitación. Dichos elementos se hallan acoplados a sus vecinos inmediatos mediante procesos difusivos, los cuales permiten que se propaguen los potenciales de acción. Acorde con esta perspectiva, al tratar de estudiar ya no lo que ocurre en una sola célula sino en conjuntos de ellas que interaccionan, se pasa a niveles superiores de organización, por lo que no hay que dejarse arrastrar por la tentación mecanicista que lleva a extender o superponer lo que ocurre a nivel individual (una célula cardiaca) a todo un conglomerado, que tal vez esté formado por millones de células. En efecto, el todo se encuentra integrado por elementos que individualmente son osciladores excitables y contráctiles. De hecho, al cambiar de escala espacial, todas las células constituyen un órgano cuyo funcionamiento semeja el de un gran oscilador excitable y contráctil.
Entre diversos factores, la no homogeneidad del músculo cardiaco desempeña una función central; las células cardiacas se encuentran agrupadas en fibras de forma casi cilíndrica, que en conjunto integran capas las cuales, a primera vista, pudieran considerarse paralelas. Sin embargo, la orientación de dichas fibras cambia sustancialmente desde las capas más superficiales, hasta las más internas del músculo cardiaco. Por ejemplo, en los ventrículos su orientación varía continuamente desde el epicardio hasta el endocardio, y llega a tener una diferencia entre esos dos extremos hasta de 180°. Lo anterior se refleja en el hecho de que la conductibilidad eléctrica del músculo no es constante, sino que depende de la dirección en la que se propaga el potencial de acción. Por tanto, el músculo cardiaco constituye un medio excitable anisotrópico de dimensión tres. Cabe aclarar que amén de otros factores, la anisotropía es un elemento muy importante que deben incorporar los modelos matemáticos que pretendan describir la propagación del potencial de acción por el miocardio.
Si se atiende a la forma como se incorporan las variables tiempo y espacio en los modelos matemáticos, éstos pueden pertenecer a cualquiera de las dos grandes familias que se describen y revisan a continuación.
Modelos discretos. Los investigadores pioneros de este enfoque en relación al funcionamiento cardiaco fueron el matemático estadounidense Norbert Wiener y el fisiólogo mexicano Arturo Rosenblueth,(NOTA 32) que en 1946 publicaron un trabajo que sin duda se ha convertido en referencia obligada para quienes estudian este tipo de modelos sobre la propagación de ondas en medios excitables. El modelo propuesto por estos estudiosos que, según la clasificación dada arriba, es de tipo global, y se refiere a un autómata celular(NOTA 33) determinista en el que cada célula se representa como un punto en una rejilla regular. El espacio correspondiente a los estados posibles comprende tres elementos: estado de reposo (R), de excitación (E) y refractario (Ref), sujetos a reglas de evolución locales que incluyen la transición del estado R al E (regla de propagación), siempre que al menos una célula vecina se encuentre en el estado E. Weiner y Rosenblueth estudiaron el efecto que produce la no homogeneidad del medio excitable en la propagación de ondas re-entrantes. Unas décadas después, este planteamiento fue mejorado por una serie de investigadores, que introdujeron varios tipos de autómatas celulares con el fin de mejorar las deficiencias observadas en los más primitivos. Entre ellos se pueden citar Moe et al,(NOTA 34) Greenberg y Hastings,(NOTA 35) cuyos autómatas celulares exhiben propagación de ondas. Sin embargo, según Gerhardt et al, (NOTA 36) estas proposiciones tienen fallas en varios aspectos cruciales como el no considerar el efecto de la curvatura de la onda de excitación sobre la velocidad con la cual se propaga. Esta objeción es cierta, pues por medio de otra metodología, se demostró(NOTA 37) que la velocidad v de propagación del frente de onda en dirección normal en un medio excitable, la velocidad c de un frente plano, el coeficiente de difusión D del medio y la curvatura k del frente se relacionan a través de la llamada ecuación de la eikonal v = c + Dk. Dado que k depende del sentido de la curvatura del frente, entonces la expresión anterior indica que si se halla curvado hacia atrás, viaja más rápido; mientras que si está curvado hacia adelante, se desplaza más lentamente. Resulta obvio que la velocidad de un frente de activación en forma de onda plana tiene un valor intermedio. Lo importante es que en los autómatas celulares entes mencionados, no se incluye la curvatura. Otro punto débil que observaron estos autores es el que se refiere a la no homogeneidad del medio que, como ya se indicó, desempeña una función muy importante. Investigaciones posteriores abordaron cada uno de los puntos endebles; por ejemplo, Gerhardt et al (NOTA 38) propusieron un autómata celular de segunda generación con el fin de considerar el efecto de la curvatura; mientras que Weimar et al (NOTA 39) introdujeron otro de tercera generación que combina las fortalezas de varios de ellos y evita las debilidades de las versiones previas.
También se han propuesto otras familias de sistemas dinámicos discretos para estudiar otros aspectos de la dinámica cardiaca. Por ejemplo, las ecuaciones en diferencias no lineales que provienen del estudio de la respuesta de las células cardiacas ante estímulos aplicados periódicamente. En efecto, dicha respuesta no siempre es del mismo tipo, ya que se observan cambios cuantitativos en ella, los cuales se manifiestan durante el tiempo que dura la fase de meseta del potencial de acción. Las llamadas curvas de restitución eléctrica relacionan el ancho del potencial de acción con el tiempo de descanso inmediato anterior, a partir de lo cual, si se considera una sucesión de estímulos y los consiguientes anchos de respuestas, se llega a una ecuación en diferencia no lineal en la que aparece un parámetro. El análisis de la dinámica asociada a esta ecuación sugiere la existencia de comportamientos caóticos en cierto rango de valores del parámetro. Para más información sobre el tema, véase el trabajo de González (NOTA 40) y las referencias que ahí se citan.
Modelos continuos. Aunque Hodgkin y Huxley plantearon originalmente su modelo para describir la propagación de impulsos nerviosos a través del axón, con las debidas adaptaciones también se convirtió en un punto de partida para la construcción de otros modelos matemáticos que permitieran describir el potencial de acción, primero en células cardiacas y después en porciones de músculo. Bajo la premisa de la fijación del voltaje, en 1962 el fisiólogo inglés Denis Noble(NOTA 41) propuso un modelo de corrientes iónicas y conductancias del tipo Hodgkin-Huxley, con el fin de describir el potencial de acción en las células cardiacas que forman las fibras de Purkinje. Sólo consideró las corrientes de potasio y sodio, pues aunque la de calcio es fundamental, en esa época aún no había sido descubierta. Consideró que la contribución del potasio estaba dada por dos corrientes: una que fluía hacia fuera con una conductancia igual a la usada por Hodgkin-Huxley, y supuso que la otra conductancia era una función dependiente del potencial de acción. La corriente de sodio la representó con la correspondiente ecuación que para este elemento propusieron Hodgkin y Huxley. El modelo de Noble consiste en un sistema no lineal de cuatro ecuaciones diferenciales ordinarias, una de ellas para el potencial de acción. A pesar de las deficiencias señaladas posteriormente, en un acto de justicia debe decirse que este fisiólogo fue uno de los primeros que introdujo modelos matemáticos de tipo continuo para describir la dinámica cardiaca. Las soluciones numéricas de su modelo reproducen las características cualitativas del potencial de acción en las fibras de Pukinje. Sin embargo, las bases fisiológicas sobre las que lo construyó son incorrectas, entre otras razones, porque lo hizo antes de que la técnica de fijación del voltaje para las células cardiacas estuviera probada y porque no incorpora la corriente de los iones de calcio.
Conforme el desarrollo de las técnicas experimentales, la investigación clínica y de laboratorio sobre la electrofisiología cardiaca, llevaron a obtener una gran cantidad de datos sobre los mecanismos biofísicos subyacentes al potencial de acción cardiaco, se modificaron los modelos (aunque conservaron las características esenciales del modelo de Hodgkin-Huxley). A esta segunda generación de modelos pertenece —entre otros muchos— el que propusieron McAllister et al,(NOTA 42) en 1975, para la actividad eléctrica de las fibras de Purkinje, la cual incluye más corrientes iónicas, pero aún se basa en el supuesto de que la actividad eléctrica la determinan sólo los canales iónicos. En 1977 Beeler y Reuter(NOTA 43) dieron a conocer un modelo en el cual usaron cuatro (de ocho) de las diferentes conductancias iónicas en el músculo cardiaco que entonces se conocían. En 1985, DiFrancesco y Noble(NOTA 44) plantearon un modelo electrofisiológico que incorporó por primera vez, de manera explícita, los cambios en las concentraciones iónicas y la actividad de las bombas e intercambiadores iónicos en la actividad de los canales iónicos. No obstante, su propuesta fue objeto, a su vez, de una serie de observaciones hechas por Guan et al.(NOTA 45)
En 1991, Luo y Rudy(NOTA 46) expusieron, basados en el modelo de Beeler y Reuter, lo que en la literatura especializada se denomina la fase uno de un modelo iónico para el potencial de acción en células ventriculares del cerdo de guinea; consideraron seis nuevas corrientes y usaron nueve variables. Tres años después estos mismos investigadores, ahora apoyados en el modelo de DiFranceso y Noble,(NOTA 47) construyeron un modelo para el potencial de acción, en el cual incluyeron más elementos iónicos que habían hallado en células cardiacas, tales como las bombas iónicas y los intercambiadores; también corrigieron la velocidad de activación de la corriente de calcio. Un año después, Rudy y colaboradores(NOTA 48) hicieron otra aportación en la cual añadieron dos nuevas corrientes y ajustaron las otras, lo que en total dio por resultado 17 corrientes diferentes. La formulación matemática de este modelo se hace en términos de un sistema de 11 ecuaciones diferenciales correspondientes a las variables relevantes, entre las que se incluye el potencial de acción.
Como el lector habrá notado, en este breve recuento se ha partido de modelos relativamente sencillos, que, debido a que fueron construidos sobre bases erróneas, resultaron insuficientes para elaborar la descripción deseada, hasta otros que en su pretensión de ser más exhaustivos, involucran muchas más variables, por lo que plantean grandes dificultades para su estudio. En este punto aparece una disyuntiva frecuente en todo proceso de modelación matemática: o se construyen modelos que pretendan ser exhaustivos aunque inmanejables como para que se pueda extraer de ellos alguna información relevante, o se opta por modelos cualitativos más sencillos, más accesibles al análisis y que capturen la esencia cualitativa del proceso en estudio. A todas luces esta segunda opción, resulta atractiva e incluso ya ha sido explorada por otros investigadores. Por ejemplo, en 1993 Karma(NOTA 49) planteó un modelo simplificado en el que, más que fijarse en el comportamiento individual de cada corriente iónica, centró su atención en actuación colectiva de ellas, y formuló un modelo matemático que consta solamente de dos variables. En esta misma línea, valdría la pena explorar la eventual reformulación de modelos tan complicados como el de Luo-Rudy en términos de variables lentas y variables rápidas con la finalidad de lograr una simplificación como la que realizaron FitzHugh y Nagumo al modelo original de Hodgkin y Huxley.
Antes de terminar esta revisión, se debe apuntar que si se elimina la premisa de fijación del voltaje, entonces los modelos matemáticos descritos anteriormente habrán de modificarse para que tomen en cuenta las variaciones espacial y temporal de las variables relevantes. A su vez, el tipo de modelo que se construya dependerá de la finura con la que se incorporen las variables espaciales. Por ejemplo, el llamado modelo del bidominio para una célula cardiaca considera dos medios: el intracelular y el extracelular (separados por la membrana), cada uno con conductividad propia. En la versión más simple, se puede suponer que una y otra son constantes, de lo que se deriva que la parte estrictamente difusiva se obtiene a partir de la ley de conservación. Sin embargo, en un nivel de mayor realismo se debe considerar la propagación entre células cardiacas y si, como dijimos antes, resulta razonable la hipótesis de que se forman capas, entonces ha de incorporarse la anisotropía del medio excitable. En esta dirección hay aportaciones interesantes, por ejemplo, la hecha por el grupo de Auckland, Nueva Zelanda, encabezado por Peter Hunter, que con base en la mecánica del medio continuo y considerando los procesos electroquímicos involucrados, propuso un modelo electromecánico para el corazón.
En lo que atañe al uso de la matemática para tratar de entender el fenómeno de la propagación de ondas en el músculo cardiaco, específicamente en los ventrículos, José Jalife,(NOTA 50) quien es un científico que ha hecho importantes contribuciones en esta área, expresa lo siguiente:
“La aplicación reciente de la teoría de la dinámica no lineal a la propagación de ondas en el corazón, junto con las técnicas de mapeos de alta resolución, ha permitido a los investigadores concebir la fibrilación ventricular como un problema de autoorganización de ondas eléctricas no lineales con componentes deterministas y estocásticos. Esto ha conducido a la aplicación de nuevos enfoques experimentales y numéricos al estudio de los patrones de excitación de dimensión dos y tres que surgen en la fibrilación ventricular.”
Más adelante añade:
“Aunque tradicionalmente se ha creído que la fibrilación en el corazón humano es el resultado de un gran número de ondas que viajan sin rumbo alguno, los mecanismos detallados de la fibrilación continúan no siendo claros. Los avances recientes en la tecnología de los mapeos ópticos han hecho posible demostrar que, en corazones pequeños como los de conejos o ratones, incluso una sola onda enrollada puede dar origen a un ECG cuyo patrón es parecido al observado en la fibrilación ventricular. Sin embargo, en corazones grandes patrones de organización espacio-temporal más complejos son los que normalmente imperan. Por lo tanto, parece razonable que en el caso del corazón humano se dé la autoorganización bajo la forma de un número relativamente pequeño de ondas enrolladas que interaccionan entre ellas para producir patrones espacio-temporales complejos.”
Con estas citas, cuyo contenido retomamos en la sección final de este capítulo —desde una perspectiva más global—, concluimos la presentación tanto de la fenomenología como de la descripción de los modelos que surgen de la formulación matemática correspondiente, para dar lugar a otro tema fascinante de la ciencia que, en primera instancia, parece por completo ajeno a los fenómenos cardiacos.
Dos sistemas distantes que comparten cualidades
La historia de la ciencia semeja una fuente inagotable de sorpresas, pues investigaciones que en apariencia nada comparten, no sólo porque los sistemas sobre los que se llevan a cabo son por completo diferentes, sino porque, además, la metodología que cada una de ellas utiliza es totalmente diferente, a fin de cuentas convergen en un mismo marco conceptual y dichos sistemas pueden, si se les mira desde una óptica apropiada, ser visitos como manifestaciones distintas de algo que los unifica. El caso que en concreto se presenta al lector en esta sección es particularmente paradigmático, pues unifica dentro de un mismo marco conceptual investigaciones fundamentales en biología matemática que ya son clásicas en esta área del conocimiento. Nos referimos a un conjunto de reacciones químicas que se agrupan bajo el nombre genérico de reacción de Belousov y Zhabotinsky, y al fenómeno de propagación del potencial de acción por el músculo cardiaco. La presentación(NOTA 51) se inicia con una descripción sucinta de esta afamada reacción química.
En los primeros años del decenio de 1950, varios bioquímicos se interesaban en entender la cadena de reacciones que participaban en el metabolismo de organismos aeróbicos, es decir, de animales, plantas y muchos microorganismos. Específicamente en lo que se refiere al ciclo del ácido cítrico, el cual comprende una serie de reacciones bioquímicas que se llevan a cabo dentro de la célula, y cuyo resultado final es la formación de bióxido de carbono, agua y energía. Uno de esos estudiosos era el bioquímico de origen alemán y nacionalizado inglés Hans Adolf Krebs, quien descubrió el ciclo del ácido cítrico (ahora en su honor, es llamado ciclo de Krebs). Por este trabajo, junto con el realizado por el también investigador de origen alemán y nacionalizado estadounidense, Fritz Albert Lipmann, sobre “…el descubrimiento de la co-enzima A y su importancia en el metabolismo intermediario”, les fue conferido el Premio Nobel de Fisiología o Medicina 1953. En la figura 15 se muestra un diagrama del ciclo de Krebs.
Por otro lado, en la ex Unión Soviética, el bioquímico Boris Pavlovich Belousov en vez de estudiar al detalle todas y cada una de las reacciones del ciclo de Krebs, emprendió una búsqueda de otro tipo: le interesaba hallar un mecanismo relativamente sencillo, algo de simple reproducción en el laboratorio, pero que capturara los aspectos cualitativos del ciclo metabólico. Además le importaba elaborar un modelo químico sencillo sobre la oxidación de moléculas orgánicas en las células vivas.

Figura 15
Acorde con su objetivo, su tarea consistió en crear una caricatura inorgánica del ciclo del ácido cítrico oxidándolo, no con enzimas catalíticas, sino con iones metálicos que las enzimas suelen tener en sus sitios activos. Para ello, seleccionó el cerio y le dio a la solución un tono ligeramente amarillo, además reemplazó el cofactor NAD de las enzimas oxidantes por bromato inorgánico en una solución de ácido sulfúrico. Lo que Belousov observó en su tubo de ensayo, fue una solución que fluctuaba una y otra vez entre amarillo pálido y la falta de coloración, así, sin proponérselo construyó el ¡primer oscilador químico! El investigador ruso buscó publicar el resultado de sus experimentos en una revista especializada. La primera vez que lo hizo, los árbitros le recomendaron que refinara sus experimentos, ya que, de acuerdo al conocimiento que había en esos años, más bien las concentraciones debían tener una tendencia monótona (sin oscilaciones) hacia el equilibrio de la solución, sin color a un amarillo pálido. La historia siguiente sobre los esfuerzos que hubo de realizar para dar a conocer a la comunidad científica sus hallazgos resulta más bien triste y puede leerse ya sea en el libro de Winfree(NOTA 52) o en el escrito hecho por el mismo autor.(NOTA 53) Para los fines de esta exposición, baste decir que para fortuna de la dinámica no lineal, en particular en el contexto de las oscilaciones químicas, otros bioquímicos rusos conocieron y se interesaron mucho por los trabajos pioneros de Belousov. Uno de ellos fue el joven Anatoly M. Zhabotinsky, quien, a principios de la década de 1970, empezó su doctorado bajo la guía de S.E. Schnoll, un científico a quien Belousov le había confiado la receta de la reacción. El trabajo que se le encomendó al joven estudiante consistía en estudiar con detalle los mecanismos subyacentes bajo la reacción ideada por Belousov, así como averiguar sus posibles extensiones. Lo primero que hizo Zhabotinsky fue reemplazar algunos de los reactivos con el objetivo de obtener colores más contrastantes. Para ello disolvió en agua, en proporciones adecuadas, ácido sulfúrico, ácido malónico, bromato de potasio y sales de hierro y cerio. Así, en vez de las oscilaciones amarillo-incoloro-amarillo obtenidas por Belousov, obtuvo otras que fluctuaban de rojo a azul y de azul a rojo. Una de las extensiones llevadas a cabo por Zhabotinsky consistió en averiguar el efecto que tiene la dimensión del espacio físico en el que se efectúa la reacción. Para empezar, realizó los experimentos en una caja de Petri, con una capa de solución lo suficientemente delgada como para pensar que la tercera dimensión (la profundidad) no era relevante. Una de las primeras cosas que observó fueron los frentes de concentración química de forma circular que se propagaban, de manera similar a como ocurre cuando se tira una piedra en un charco de agua y viajan ondas concéntricas. En la literatura a este tipo de patrones se denominan patrones de tipo blanco (véase figura 16 donde aparecen ilustrados). (NOTA 54)
Una ligera perturbación (por ejemplo, bajo la forma de una inhomogeneidad) en los patrones tipo blanco basta para destruirlos y dar origen a otro tipo de patrones bidimensionales: frentes de concentración química en forma de espiral, los cuales por el hecho de propagarse no de cualquier forma sino precisamente rotando, dan lugar entonces a patrones en movimiento de concentración que comparten propiedades cualitativas con los frentes de activación que se observan en los casos de fibrilación presentados en la sección anterior. En la figura 17 se ven dos espirales rotando, cada una lo hace en sentido opuesto.
También se hicieron experimentos en los que la profundidad del recipiente donde la reacción se efectúa es importante. Lo que se contempló en ese mismo tipo de reacciones fueron estructuras espaciales en movimiento, cuyas características cualitativas son similares a las de la onda chocorrol que se mencionó en la sección anterior. Esta vez se trata de una onda de concentración que semeja una hoja de papel que se enrolla a medida que la reacción se lleva a cabo. Este patrón puede apreciarse en la figura 18.

Figura 16
Arthur Winfree, quien no sólo fue la persona que más difundió el trabajo de Belousov y Zhabotinskii en occidente, sino que, además, hizo aportaciones notables para que se comprendiera el fenómeno de propagación de ondas en medios excitables, al principio se mostró incrédulo y lo expresó en los siguientes términos: (NOTA 55)
“Aun en el otoño de 1968 estando en Praga, que fue cuando por primera vez me enteré a través de Zhabotinskii, un compañero estudiante de posgrado, de la reacción de Belousov, mis sentimientos fluctuaban entre el asombro y el escepticismo. Meses más tarde, en Princeton, con la receta de Zhabotinskii en la mano, puse un recipiente que contenía la mezcla en un espectrofotómetro. La pluma se deslizó a la izquierda cuando el líquido se obscureció en las bandas invisibles ultravioleta, después —lenta, pausada— regresó. ¡El contenido del recipiente se estaba poniendo claro! Pero entonces la claridad se tornó otra vez oscura de forma lenta, pausada, hacia la extinción…El teléfono sonó; cuando regresé había un ritmo de densidad óptica en la región del ultravioleta invisible.”

Figura 17
La matemática ha desempeñado un papel muy importante como instrumento para describir los mecanismos de la reacción de Belousov-Zhabotinskii. Por ejemplo, en 1972 Field, Köros y Noyes propusieron un mecanismo(NOTA 56) que consta de tres etapas: en la primera, compuestos que contienen bromo intercambian átomos en una serie de reacciones de oxidación-reducción; en la segunda, el bromato reacciona inicialmente con HBrO. Dos años después, Field y Noyes expusieron una cinética que, no obstante su sencillez, captura muchas de las cualidades de la reacción de Belousov-Zhabotinskii; dicha cinética se reduce a tres reactivos, cuya concentración, cuando se hace uso de la ley de Acción de Masas, satisface un sistema no lineal de tres ecuaciones diferenciales ordinarias, el cual, a su vez, se reduce a sólo dos ecuaciones, ya que se observa que los valores que toma uno de los parámetros son muy pequeños (una reducción similar a la hecha en el sistema de Hodgkin-Huxley). Para diferentes valores de un parámetro, la dinámica de este sistema incluye: la tendencia de las concentraciones hacia un estado de equilibrio, la aparición de oscilaciones periódicas (respecto al tiempo) en las concentraciones y el fenómeno de excitabilidad.

Figura 18
Comentarios finales
En este capítulo se ha bosquejado, principalmente, el uso de un elemento matemático (los sistemas de ecuaciones diferenciales parciales no lineales) con el fin de exponer algunos de los mecanismos que se hallan detrás de la emergencia de patrones en diferentes sistemas. Sin embargo, cabe aclarar que hay varios enfoques. En términos sencillos, los modelos matemáticos que hasta ahora se han usado para ese fin, son de dos tipos: continuos y discretos. Con una larga tradición en matemática, los sistemas no lineales de ecuaciones diferenciales parciales son representativos del primer tipo. Dentro de éstos, se ha presentado la emergencia de patrones basados en un rompimiento de simetría: la bifurcación de Turing. Según este mismo enfoque, hay otras bifurcaciones a partir de las cuales también se originan patrones. Una de ellas es la de Hopf, en la cual, en vez de una distribución espacial estable ante perturbaciones temporales (pero inestable a perturbaciones espacio-temporales como ocurre en la bifurcación de Turing) se da el rompimiento de oscilaciones periódicas en términos de la concentración de los morfógenos.
Así mismo es posible incorporar otros procesos que —según la evidencia fenomenológica— influyen de forma decisiva en la emergencia de algunos patrones. Uno de ellos es la quimiotaxis, fenómeno mediante el cual individuos se mueven en respuesta a sustancias químicas que emiten otros miembros de la misma población. Un ejemplo muy interesante de esto, lo constituye la amiba Dictyostelium discoideum, que vive en lugares pantanosos. Cuando las condiciones ambientales son hostiles, un grupo de ellas emite una señal bajo la forma de adenosina de monofosfato cíclico (cAMP), la cual es percibida por otro grupo y empieza a moverse hacia el sitio de emisión. La ruta que siguen para dirigirse hacia dicho sitio no es rectilínea, sino que lo hacen siguiendo una trayectoria en espiral. Esta fase de agregación de la Dictyostelium forma parte de su ciclo de vida durante el cual se observan, además, varios procesos fundamentales en su morfogénesis como migración, adhesión, diferenciación, etc., que son fundamentales en distintos procesos morfogenéticos. Si el lector desea obtener más detalles sobre el particular, pueden consultar el libro escrito por Kessin, (NOTA 57)
Según la forma como se incorpore la discretización del espacio en el que emergen los patrones o el tiempo, hay varios tipos de modelos discretos. Así, lo mismo se habla de distintos tipos de autómatas celulares, de mapeos acoplados que de modelos que simulan algunos procesos específicos como la agregación limitada por difusión. Los autómatas celulares en el contexto de la morfogénesis, tratan de reflejar el hecho de que a cierto nivel de organización, los animales y las plantas están formados por elementos discretos: las células. De hecho, para un órgano o tejido dados, el número de tipos de células es pequeño por lo que resulta razonable pensar que existe una célula básica la cual, a su vez, puede tener un número finito (pequeño) de estados.
Las células interaccionan con sus vecinas inmediatas en virtud de las fuerzas entre macromoléculas y sus respectivas superficies. Si se tiene esto en mente, es plausible suponer enfoques intrínsecamente discretos que permiten estudiar la emergencia de patrones en organismos vivos: los autómatas celulares. Este término alude a sistemas dinámicos definidos sobre un dominio espacial discreto (las células) y cada elemento del dominio puede hallarse en un número reducido de estados posibles. Así, dada una distribución inicial de estados y una regla de interacción entre las células, el autómata evoluciona de generación en generación. Por ejemplo, para un autómata de dimensión uno, cuyo número de estados, según suponemos, es dos (blanco y negro), el resultado del proceso descrito, corresponde a una colección de renglones ordenados, cada uno de los cuales contiene diferentes disposiciones de estados, por lo cual ante nuestros ojos aparece una superficie en la que, conforme a las condiciones específicas del autómata, puede reconocerse una estructura ordenada o patrón. En el contexto de sistemas excitables, los estados en los que pueden hallarse las células son tres: estacionario, excitable y refractario.
Las reglas de evolución pueden ser fijas o bien variar de una generación a otra. La forma como lo hagan a su vez puede ser determinista o al azar. El libro escrito por Deutsch y Dormann(NOTA 58) constituye una referencia reciente, completa y muy documentada sobre la perspectiva de autómatas celulares en la emergencia de patrones en los sistemas biológicos.
Se llama la atención del lector para que considere el hecho de que ante la diversidad de modelos matemáticos, bien puede ocurrir (de hecho ocurre) que diferentes modelos —por medio de simulaciones numéricas adecuadas— reproduzcan un mismo patrón. Entonces de manera natural surge la pregunta: ¿cuál es el “bueno”? En opinión del autor de este capítulo no basta con reproducir razonablemente bien los patrones observados, sino que el verdadero criterio consiste en que —conforme a la visión según la cual la realidad y sólo la realidad constituye la única fuente de la verdad— los mecanismos propuestos como causantes de la emergencia de patrones tengan bases fenomenológicas que los hagan plausibles.
Por otro lado, como se ha mostrado en estas líneas, también sucede que los patrones que comparten cualidades se originan en sistemas muy diferentes sin importar que se trate de materia viva o no. Este hecho lleva a reforzar la convicción, como ya lo adelantaba D’Arcy Thompson, de que, subyacente a la emergencia de patrones, existen mecanismos universales de generación de los mismos. Al respecto, cabe mencionar el planteamiento que a la letra dice:(NOTA 59)
“Matematizar una disciplina es penetrar los objetos de estudio para encontrar en ellos lo esencial y acotar lo contingente. Es poner en práctica una concepción del mundo según la cual se pueden postular principios generales de organización de donde deducir las leyes de la naturaleza, representarla en cuerpos de teoremas —como los de la geometría euclideana— y comprenderla al descubrir en ella las relaciones estructurales o dinámicas que la hacen esencialmente inteligible.”
Nuestras búsquedas deben ir en pos de lo genérico, pues quedarse en los detalles, aunque importantes a cierto nivel y en cada caso específico, pueden impedir que se vea el bosque, según reza un conocido refrán.
La presentación que se ha hecho es más bien de carácter conceptual, sin embargo, el lector puede consultar los aspectos más técnicos en las referencias bibliográficas. En este capítulo se ha dado una visión panorámica de un área de la biología matemática con muchas y diversas ramificaciones: la morfogénesis. Así mismo se ha mostrado que la emergencia de patrones proviene de procesos de autoorganización en los sistemas que corresponden a efectos cooperativos no lineales entre los elementos que los constituyen. Es posible afirmar sin duda alguna que el trabajo que actualmente se hace en muchas instituciones académicas y no académicas, en diversas partes del mundo, en relación a la matemática de lo no lineal en ciencias de la vida, en particular en morfogénesis, propagación de ondas en medios excitables y tantas otras áreas, concuerda con la perspectiva de Ian Stewart, quien en 1998 escribió: (NOTA 60)
“Una de las áreas de crecimiento más emocionantes de la ciencia del siglo XXI serán las biomatemáticas, el siguiente siglo atestiguará una explosión de nuevos conceptos matemáticos, de nuevas clases de matemáticas construidas por la necesidad de entender los patrones del mundo viviente, esas nuevas ideas interactuarán con las ciencias físicas y biológicas de forma totalmente nueva; ellas si son exitosas, proveerán un entendimiento profundo de ese extraño fenómeno que llamamos vida.”
Por ello es muy importante que los científicos de las ciencias de la vida que laboran en el medio mexicano, hagan a un lado prejuicios y remuevan inercias a fin de que incorporen en su quehacer cotidiano metodologías, conceptos y técnicas de la dinámica no lineal. De esta manera, trascenderán los enfoques puramente descriptivos, que, aunque importantes a cierto nivel, son insuficientes para responder preguntas fundamentales en sus respectivas áreas de conocimiento. Indudablemente también es imperativo hacer un llamado a los estudiosos de las denominadas “ciencias duras” a fin de que sin soberbia, con mente abierta y sobre todo con gran sentido de colaboración, se asomen a las ciencias de la vida en donde, además de aprender mucho, encontrarán formidables retos intelectuales.
Concluimos con una reflexión para el lector: si al terminar la lectura de este capítulo se sienten atraídos por el tema que se desarrolla en él como para iniciar incursiones propias, nuestro esfuerzo no habrá sido en vano y, en tal caso, nos sentiremos más que satisfechos.
(NOTA 1) Del libro: Las ciencias de la complejidad y la innovación médica, Ensayos y Modelos. Coordinadores: Enrique Ruelas Barajas, Ricardo Mansilla, Javier Rosado. México, Secretaría de Salud e Instituto de Física del Centro de Investigaciones Interdisciplinarias en Ciencias y Humanidades, Universidad Nacional Autónoma de México, Grama Editora, S.A., 2006
(al texto)
(NOTA 2) Dr. Faustino Sánchez. Físico y matemático por la Facultad de Ciencias de la UNAM, donde también realizo sus estudios de maestría en ciencias (matemáticas). Doctor en matemáticas por la Universidad de Oxford, donde además efectuó una estancia posdoctoral. Es miembro del Sistema Nacional de Investigadores. Profesor de tiempo completo en el Departamento de Matemáticas de la Facultad de Ciencias de la UNAM, donde forma parte del Grupo de Biomatemáticas de esta dependencia universitaria.
(al texto)
Referencias bibliográficas
(NOTA 3) Palabra cuyas raíces son morfé, forma y genesis, origen.
(al texto)
(NOTA 4) Thompson, W. D’Arcy: On Growth and Form. The Complete Revised Edition. Dover Publications Inc., 1992.
(al texto)
(NOTA 5) Thompson, W.: Op. cit.
(al texto)
(NOTA 6) En: Morphogenesis, collected works of A.M. Turing. P.T. Saunders (Editor), North-Holland, 1992, el lector encontrará otro par de artículos dedicados al tema, escritos y publicados después de la muerte de Turing. En ellos sus autores plantean lo que llaman la teoría morfogenética de la filotaxia.
(al texto)
(NOTA 7) A. M. Turing: The chemical basis of morphogenesis. Phil. Trans. R. Soc. Lond. B 1952 (237):37-72.
(al texto)
(NOTA 8) Dos de éstas son:
J.D. Murray, Mathematical Biology, Vol II. Springer 2003.
Sánchez Garduño F, Padilla P. Emergencia y formación de patrones en biología: un enfoque matemático. En: Biología matemática, un enfoque desde los sistemas dinámicos. Esteva L, Falconi M (compiladores). Prensas de la Facultad de Ciencias, UNAM, 2002:125-161.
(al texto)
(NOTA 9) Se puede encontrar una presentación introductoria a estos temas en: Sánchez Garduño F. Matemáticas y química: Una mirada a la cinética química desde la matemática. Serie Matemática Aplicada y su Enseñanza. Tema: Matemáticas para Ciencias de la Vida. Sociedad Matemática Mexicana-CIMAT, 2004.
(al texto)
(NOTA 10) Estas condiciones pueden consultarse en cualquiera de las dos referencias antes mencionadas.
(al texto)
(NOTA 11) La no linealidad de las ecuaciones proviene de la parte cinética en la que, además, aparecen parámetros de importante interpretación química. La no linealidad, junto con la aparición de varios parámetros, hace que los estudios —por métodos analíticos— no sean una tarea fácil. Sin embargo, esta característica le confiere gran riqueza dinámica. La obtención de soluciones analíticas explícitas para tales sistemas es sólo un sueño y no una realidad, razón por la cual la mayoría de los estudios que actualmente se hacen son de tipo numérico. En éstos, con el auxilio de la computadora, se obtienen soluciones aproximadas o numéricas al sistema en cuestión, es decir, la concentración de las sustancias reaccionantes en todo punto de la región considerada y para todo tiempo.
(al texto)
(NOTA 12) Op. cit.
(al texto)
(NOTA 13) En el artículo de Pablo Padilla y el autor de este capítulo se presenta una descripción de este proceso.
(al texto)
(NOTA 14) Las siguientes son algunas de las críticas para un sistemas específico, ¿cuáles son los morfógenos? Al comparar los patrones que presenta la teoría de Turing con los observados en sistemas reales, cabe preguntar, ¿qué tan parecidos son? Es decir, ¿qué tan reales son los patrones de Turing? Véase el trabajo, antes mencionado, de Pablo Padilla y el autor de este capítulo.
(al texto)
(NOTA 15) Plaza RG, Sánchez-Garduño F, Padilla P, Barrio R, Maini PK. The Effect of Growth and Curvature on Pattern Formation. Journal of Dynamics and Differential Equations 2004; 16, (4):1093-1121.
(al texto)
(NOTA 16) Los estudios previos aquí referidos pueden consultarse, entre otros, en: Barrio RA, Varea C, Aragón J.L, Maini PK. A two-dimensional numerical study of spatial pattern formation in interacting Turing systems. Bull Math. Biol. 1999;61: 483-505
(al texto)
(NOTA 17) Aunque en la figura todos los cuadrados aparecen del mismo tamaño, en realidad cada uno de ellos es diferente. El orden en el que crecen es de izquierda a derecha y de arriba hacia abajo. Así, el cuadrado del extremo inferior derecho es aproximadamente 4.5 veces más grande que el del extremo superior izquierdo.
(al texto)
(NOTA 18) La misma acotación respecto a los tamaños hecha en la nota anterior es válida aquí. Al ponerlos del mismo tamaño es posible visualizar rápidamente los cambios cualitativos en la distribución de la concentración del morfógeno.
(al texto)
(NOTA 19) Tanto en la membrana neuronal, como en el medio que rodea a la célula, se encuentran distintos tipos de iones, principalmente de sodio (Na), potasio (K) y cloro (Cl).
(al texto)
(NOTA 20) Traducción del autor de este capítulo del término voltage clamp.
(al texto)
(NOTA 21) Keener J, Sneyd J. Mathematical Physiology. Springer 1998. También en el artículo: Excitabilidad y autoorganización de algunos sistemas complejos, escrito por el autor de este capítulo y Pablo Padilla, que aparecerá próximamente en la revista Ciencias de la Facultad de Ciencias de la UNAM, el lector puede encontrar una versión introductoria a estos temas.
(al texto)
(NOTA 22) La aproximación numérica que ellos obtuvieron para la velocidad fue de 18.8 m/seg, mientras que el valor experimental de ésta fue de 21.2 m/segundo.
(al texto)
(NOTA 23) Tanto esta parte, como la presentación de la fisiología del corazón, se basan en la siguiente referencia: R. M. Berne and M.N. Levy: Principles of Physiology. Mosby, 2000.
(al texto)
(NOTA 24) Nótese que en la membrana de las células cardiacas se da, además, un flujo de iones de calcio, lo que no ocurre en la membrana neuronal.
(al texto)
(NOTA 25) Jalife J. Ventricular fibrillation: mechanisms of initiation and maintenance. Ann Rev Physiol 2000;62:25-50. Éste es un excelente trabajo de revisión no sólo de las teorías existentes relativas a los mecanismos que originan y mantienen la fibrilación cardiaca, sino también sobre los patrones espacio-temporales con ella asociados y el uso de la dinámica no lineal en este contexto.
(al texto)
(NOTA 26) Véase: Courtemanche M, Vinet A. Reentry in Excitable Media. En: Nonlinear Dynamics in Physiology and Medicine. Beuter A, Glass L, Mackey MC, Titcombe MS (editors). Springer 2003. Los artículos que forman el libro contienen abundantes referencias.
(al texto)
(NOTA 27) El frente de activación lo define el conjunto de puntos sobre el músculo cardiaco a los que les corresponde el mismo potencial de acción.
(al texto)
(NOTA 28) La forma común en la que la fibrilación se interrumpe consiste en aplicar choques eléctricos de suficiente intensidad. La explicación de por qué estas técnicas de defibrilación funcionan aún no son del todo satisfactorias.
(al texto)
(NOTA 29) Los primeros estudios de este tipo fueron realizados en tejidos del corazón de conejos. Los experimentos los llevaron a cabo Maurits Allesie y cols. en la década de 1970. Sus resultados los reportaron en varios artículos. Uno de ellos, quizás el primero, es: Circus movement in rabbit atrial muscle as a mechanism of tachycardia. Circ Res 1973;44:54-62. Sin embargo, los resultados más concluyentes al respecto son más recientes; uno de los trabajos en los que se reportan estos resultados es: Schuessler RB, Grayson TM, Bromberg BI, Broineu JP. Cholinergically mediated arrythmias induced by single extrastimulus in the isolated canine tachicardia right atrium. Circ Res 1992;71:1254-1269.
(al texto)
(NOTA 30) Winfree AT. Suden cardiac death: a problem of topology. Sci Am 1983;248(5):144-161.
(al texto)
(NOTA 31) Una serie de tiempo constituye una colección de registros {(ti, x (ti))} con i = 1, 2,…, n de alguna variable de estado a diferentes tiempos. Los análisis no lineales de series de tiempo tratan de averiguar si esta serie corresponde a alguna dinámica descrita por alguna ecuación diferencial y, en su caso, investiga la existencia de atractores, su dimensión, etcétera.
(al texto)
(NOTA 32) Wiener N, Rosenblueth R. The mathematical formulation of the problem of conduction of impulses in a network of connected excitable elements, specifically in cardiac muscle. Arch Inst Cardiol Mex 1946;16:205-265.
(al texto)
(NOTA 33) Para una descripción somera de los autómatas celulares, véase la última sección de este capítulo. Ahí mismo se dan referencias sobre la literatura más especializada.
(al texto)
(NOTA 34) Moe GK, WC, Rheinboldt, Abildskov JA. A computer model of atrial fibrillation. Am Hear J 1964;67:56-58.
(al texto)
(NOTA 35) Greenberg JM, Hastings SP. Spatial patterns for discrete models of diffusion in excitable media, SIAM J Appl Math 1987;34:515-523.
(al texto)
(NOTA 36) Gerhardt M, Schuster H, Tyson JJ. A cellular automaton model of excitable media incluiding curvature and dispersion, Science 1990;247:1563-1566.
(al texto)
(NOTA 37) Véase por ejemplo Tyson JJ, Keener JP. Singular perturbation theory of travelling waves in excitable media. Phys D 1988;32:327-361.
(al texto)
(NOTA 38) Gerhardt et al. Op. cit.
(al texto)
(NOTA 39) Weimar JR, Tyson J, Watson LT. Third generation cellular automaton for modeling excitable media, En: Proc. of the Fifth SIAM Conf. on Parallel Processing for Scientific Computation, Dongarra J (editor). SIAM 1992:376-381.
(al texto)
(NOTA 40) Sánchez González I. Caos en curvas de restitución cardiaca. Tesis de licenciatura en Matemáticas, Facultad de Ciencias, UNAM, 2005.
(al texto)
(NOTA 41) Noble D. A modification of Hodgkin-Huxley equations applicable to Purkinje fiber action and pacemaker potential. J Physiol 1962;160:317-352.
(al texto)
(NOTA 42) Mc Allister RE, Noble D, Tsien RW. Reconstruction of the electrical activity of cardiac Purkinje fibers. J Physiol Lond 1975;251:1-59.
(al texto)
(NOTA 43) Beeler GW, Reuter H. Reconstruction of the action potential of ventricular myocardial fibers. J Physiol 1977;268:177-210.
(al texto)
(NOTA 44) DiFrancesco, Noble D. A model of cardiac electrical activity incorporating ionic pumps and concentration changes. Phil Trans R Soc London B 1985;307:353-398.
(al texto)
(NOTA 45) Guang SQ Lu, K. Huang: A discussion about the DiFranceso-Noble model. J Theor Biol 1997;189:27-32.
(al texto)
(NOTA 46) Luo C, Rudy Y. A model of the ventricular cardiac action potential. Circ Res 1991;68:1501-1526.
(al texto)
(NOTA 47) Luo C, Rudy Y. A dynamic model of the cardiac ventricular action potential. Simulations of ionic currents and concentration changes. Circ Res 1994;74:1071-1094.
(al texto)
(NOTA 48) Zeng J, Laurita KR, Rosenbaum DS, Rudy Y. Two components of the delayed rectifier K+ current in ventricular myocytes of the guinea pig type. Circ Res 1995;77:140-152.
(al texto)
(NOTA 49) Karma A. Spiral breakup in model equations of action potential propagation in cardiac tissue. Phys Rev Lett 1993;71: 1103-1106.
(al texto)
(NOTA 50) Jalife J. Op. cit.
(al texto)
(NOTA 51) El material que aquí se expone fue adaptado de la presentación que hace el autor en el libro: Matemáticas y química, una mirada a la cinética química desde las matemáticas. Op. cit.
(al texto)
(NOTA 52) Winfree AT. When Time Breaks Down. Princeton University Press, 1987. Como el lector podrá constatar, este libro expone, además, de manera brillante la propagación de ondas en medios excitables con énfasis en reacciones químicas y músculo cardiaco.
(al texto)
(NOTA 53) Sánchez Garduño F. Op. cit.
(al texto)
(NOTA 54) Traducción hecha por el autor del capítulo de la expresión en inglés target patterns.
(al texto)
(NOTA 55) Cita tomada de Winfree AT. Op. cit.
(al texto)
(NOTA 56) Field RJ, Köros E, Noyes RM. Oscillations in chemical systems. Part 2. Through analysis of temporal oscillations in the bromate-cerium-malonic systems. J Am Soc 1972;94:8649-8664.
(al texto)
(NOTA 57) Kessin RH. Dictyostelium, Evolution, cell biology and the development of multicellularity. Cambridge University Press, 2001.
También el artículo escrito por P. Padilla y el autor de este capítulo puede ser de utilidad, sobre todo en lo referente a la modelación matemática de la quimiotaxis.
(al texto)
(NOTA 58) Deutsch A, Dormann S. Cellular Automaton Modeling of Biological Pattern Formation. Birkhauser, Berlin, 2005.
(al texto)
(NOTA 59) Fragmento de la presentación que hizo el autor de este capítulo a los libros de la serie Matemáticas para las Ciencias de la Vida del proyecto SMM-CONACYT Matemáticas Aplicadas y su Enseñanza.
(al texto)
(NOTA 60) Stewart I. Life’s Other Secret, The new mathematics of the living world. Allen Lane The Penguin Press, 1998.
(al texto)
